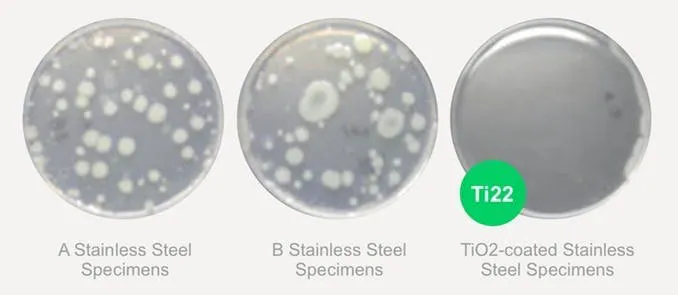

純チタン製カトラリー「Ensō 2.0(エンソー2.0)」とは
「Ensō 2.0(エンソー2.0)」は、2019年にmachi-yaで500人以上の支援を集めた「Ensō」の進化バージョン。 表面に光沢仕上げを施し美しく輝くようになったほか、箸は劇的な軽量化を達成しています。
洋の東西を問わず、何世紀にもわたり、人間が食事をするとき使われてきたカトラリーは、人類の文明の象徴と言えます。でも、食事中、1口ごとにカトラリーの素材の金属原子が1000億個も口に入っていることはあまり知られていません。カトラリーの素材は、もはや食事の一部として、料理の味や、食事をする人の健康にも影響を及ぼしています。

「Ensō 2.0(エンソー2.0)」のカトラリーは、医療現場で体内や経口のインプラントにも使用される医療グレードの高純度チタンを使っているので、安心して使用できます。
チタンはイオン化(溶け出し)しにくいため、料理の味に影響を与えることもなく、抗菌力でバクテリアの繁殖を徹底的に抑えるので常に衛生的。とても軽く、強度が強く腐食しにくいので破損や錆びとはほぼ無縁。一度買い揃えると一生ものになるカトラリーです。
「Ensō 2.0」は、machi-yaのキャンペーンで爆発的人気を博し、2800万円以上の支援を集めた純チタン製サーモボトル「Therma(サーマ)」の製作者であるTi22が製作しています。そのため、「Therma」と共通の魅力がたくさんあります。

チタンには魅力的な特性がたくさんある

地殻中に9番目に多く含まれている元素として知られているチタンは、「未来の贅沢な金属」と呼ばれ、彫刻家、建築家、科学者、デザイナー、ジュエリーメーカーがその強さと美しさを称えてきました。一方で、チタンは硬度、融点、化学耐性が他の金属より大変高いため、これまで複雑な加工を施すことは困難でした。しかしTi22は独自のイオン注入技術を開発して、滑らかで繊細なデザインのカトラリーを作ることに成功しました。
料理本来の味を邪魔しないカトラリー
食事は人間の五感で味わうものですが、カトラリーの素材が食べ物の味に影響を与えてしまう可能性があります。金属そのものにも味があり、1口ごとに約1000億個の金属原子が食べ物と一緒に口に入るからです。
原子構造が極めて安定している純チタン製の「Ensō 2.0」のカトラリーは無味無臭で、アレルギー反応が低く化学耐性が高いため、食品と舌の味蕾の間で余計なナノ化学反応が発生しません。そのため、食事中は、料理本来の味だけを純粋に楽しむことができます。これこそ、理想の食事なのです。
チタン由来の強力な抗菌力

チタンは空気に触れると、チタン原子の非常に薄い層が酸素と相互作用して、酸化チタン(IV)またはチタニアとしても知られるTiO 2(二酸化チタン)のナノコーティングを生成します。このチタニア(TiO 2)には、細菌の繁殖を防ぐ強力な抗菌効果があります。
以下は、ペトリ皿に一般的なステンレス鋼標本2種類(AとB)とチタニア(TiO2)をコーティングしたステンレス鋼標本を置いて24時間経過した時点での黄色ブドウ球菌と大腸菌コロニーの繁殖状態を示しています。チタンの抗菌力の強さは一目瞭然です。
黄色ブドウ球菌
大腸菌コロニー
低刺激性でアレルギー反応リスクが低い
チタンは低刺激性でアレルギー反応のリスクが極めて低いことから、外科医や歯科医が体内や経口のインプラントに使用しています。高純度チタン製の「Ensō 2.0」は、完全に無味無臭で低刺激性なので、ステンレス独特の味が嫌という人も貴金属で肌に炎症を起こしたことがある人も安心して使用できます。

一生ものになれる耐久性
耐腐食性が高い:チタンの腐食速度は非常に遅く、海水に4000年間漬けていても表面の海水浸透は1㎜未満です。
耐熱性が高い:アルミニウムの融点が660℃なのに対して、チタンの融点は1668℃なので、チタンは熱に対する耐性も極めて高いことになります。
熱伝導率が低い:ステンレスや他のカトラリー素材と比べて、チタンは熱伝導率が極めて低く、室温から変化しにくい性質があります。「Ensō 2.0」のスプーンなら、熱いスープやコーヒーにしばらく浸していても熱くならないので、手を火傷しそうになることはありません。

超軽量で硬度が高い:チタンは、すべての金属の中で最も強度対重量比が高いので、一般的な鋼よりもかなり硬くて軽量です。そのため、飛行機のエンジン、ドーム球場の屋根、橋梁、人工関節などに広く用いられています。
下の画像でわかるように、ステンレス製のカトラリー(左)と重量を比較すると、純チタン製の「Ensō 2.0」(右)の方がはるかに軽いことがわかります。

重いカトラリーは食事中に手が疲れてしまいます。超軽量の「Ensō 2.0」なら、楽々と自在に使いこなせます。

Ti22独自のチタンイオン注入技術で、コーティングなしでもキズ知らずに
「Ensō 2.0」が現在市販されているほとんどのチタン製カトラリーと一線を画す点は、Ti22が独自に開発した最先端のイオン注入プロセスを経ていることです。高エネルギービームでカトラリーの表面に投射されたイオンが表面に浸透して高密度のナノゾーンを作ります。これにより、カトラリーの表面の細かい凹凸が修正されて滑らかになり、表面強度と耐久性が倍増。傷が付きもののカトラリーを、ダメージ知らずのアイテムに変えてくれます。
高純度チタンの原子構造
左:イオン注入前 右:イオン注入後
高真空下で施されるこのプロセスは、カトラリーにコーティングをしないので、はく離の危険性が無く、カトラリーを加熱せずに、ビームの運動エネルギーを用いてイオンを浸透させるため、チタンの容積が変化することも高温処理に伴うリスクもありません。イオン注入技術は、人口関節、チタン製技肢などの医学的用途にも使用されています。
Ti22のイオン注入技術を駆使した「Ensō 2.0」は、耐久性と強度がアップし、信じられないほど強く、驚くほど美しいカトラリーになりました。
チタンならではの素材感と美しい光沢
「Ensō 2.0」は、製造工程で精密研磨と熱処理を繰り返すことで、チタンの素材感を活かしながら、美しく輝く光沢仕上げを実現。日々の使いやすさを考慮した機能性と息を呑むような美しいフォルムは、初めて「Ensō 2.0」を手に取る人に驚きと感動を与えます。長く使い続けても飽きのこないシンプルで美しいデザインです。
※本ページに掲載しているEnsō 2.0の写真はすべてプロトタイプです。支援者のみなさまに実際にお届けするEnsō 2.0は、より光沢がある仕上げとなっております。
さらなる軽量化を実現した純チタン製箸
Ti22は、箸を使う文化も視野に入れ、純チタン製のエレガントな箸と箸置も考案しました。金属とは思えないほど手に優しく馴染む素材感は、金属の箸のイメージを一新してくれます。チタンならではのシックな素材感が活きる一膳を、食卓に加えてみてはいかがでしょう。
「Ensō 2.0」の箸は、中空構造を採用することで、前バージョンからさらなる軽量化を実現しています(60g→17g)。
スペック
上から
ナイフ:長さ24cm、重量29g、
料理をカットしやすい鋸歯状の刃
フォーク:長さ23.1 cm、重量25g
スープスプーン:長さ22.9cm、重量31g
ティースプーン:長さ15.3cm、重量13g
箸:長さ23.1cm、重量17g
特徴:医療現場で使用されるグレードの高純度チタンを使用
スリムで超軽量
チタン由来の高い抗菌力
低刺激性でアレルギー反応リスクが低い
腐食しにくく耐久性が高い
イオン注入技術による高強度
熱伝導率が低く熱くなりにくい
無味無臭で食事の味を変えない
エコフレンドリーな高純度チタン製ストロー
エコロジーを常に意識するTi22から、使い捨てでないストローが登場しました。こちらも、医療現場で使用されるグレードの高純度チタン製です。今や全世界が取り組むプラスチックストロー使用削減に寄与するプロダクトです。
今なら、ストロー1本にクリーニングブラシが1本無料で付いてきます。
サイズ:長さ200㎜、直径6.35㎜
ナチュラルリネン素材のソフトキャリングポーチ
ナチュラルリネン素材のソフトキャリングポーチが、「Ensō 2.0」のカトラリーと合わせ買い限定で支援できます。
外出先に「マイカトラリー」を携帯したいときなどに便利です。
ハイエンドなカトラリーの収納にぴったりのハードボックス

エコフレンドリーなダークバンブー製のハードボックスは、ハイエンドなカトラリーを収納するのにふさわしい美しい仕上がりです。先にご紹介したソフトキャリングポーチが4個収納できます。
こちらも、「Ensō 2.0」のカトラリーと合わせ買い限定で支援できます。
リスクについて
このページの商品はカナダのThingyfyが売買契約における販売者となり責任を持って遂行しますが、海外との取引になる点は予めご注意ください。
この日本語のページ制作等を含め事務局スタッフ他の様々なサポートをいただきキャンペーンを進行していますが、私たちは英語が母国語のため日本語でのお問い合わせなどには回答ができない場合もある点はご承知ください。直接のお問い合わせの際は、翻訳ツールなどでできるだけ英語でいただけると助かります。
また、本製品は量産体制が確保された製品になり、募集期間終了後はできる限り早くお手元に届けられるよう努力いたします。ただし、世界的に大量の注文を受けた場合や量産計画の変更、その他予期しない不具合等での仕様変更や生産行程変更による遅延、生産工場からの発送に時間がかかることによる遅延が発生する場合があります。
また、本製品は海外より販売、発送となる為、ご購入金額等によっては到着時に関税や消費税、その他通関手数料等が発生する場合がありますのでご注意ください。
これらの点にご理解いただけない場合はお申込みをお控えください。
■特定商取引法に関する記載
◯ 販売事業者名: Thingyfy Ti22
◯ 事業者の所在地:330 Esna Park Dr #37, Markham, ON L3R 1H3, Canada
◯ 事業者の連絡先:メール:ti22@thingyfy.com (英語のみ)
※こちらでは当該製品に対するお申し込み、質問等は受け付けておりません。
◯ リターン価格:各リターン記載の通り
※ 商品内容に関してはリターン欄記載の通り
※ リターン価格とは別にcampfire(machi-ya)のシステム利用料として1支援毎に200円(税別)が支援者様の負担となります。尚、このシステム利用料はcampfireが受け取るもので、当社が受領するものではございません。
◯ 申込期限:当ページ記載のプロジェクト終了期限通り
◯ 支払い方法:クレジットカード払い(Visa/Mastercard/JCB/Diners Club/American Express)/コンビニ払い(全国の主要コンビニエンスストア)/銀行振込(銀行ATM・ネットバンキング)/auかんたん決済/ソフトバンクまとめて支払い・ワイモバイルまとめて支払い/ドコモ払い
◯ 支払い時期 :当プロジェクトは「All-in型」の為、目標達成の如何に問わず、ご契約が成立しリターンをお届けします。その為、お申込みと同時にご利用の決済方法に準じてご請求となります。
◯ 引渡し時期: 各リターン詳細に記載の発送予定月を引き渡し時期とします。但し、開発・生産状況によって遅れが生じる場合がありますのでその際は当プロジェクトページ内の「活動報告」または購入者へのメール等で連絡します。
◯ キャンセル・返品: 当プロジェクトは「All-in型」の為、お申込み完了をもって契約が成立いたします。その為、お客様都合による返品・キャンセルはできませんのでご注意ください。尚、製品到着後に破損や初期不良がある場合には交換させていただきますので「メッセージで意見や問い合わせを送る」から、または納品書記載の連絡先までお問い合わせください。
※上記以外の事項に関しては、お取引の際に請求があれば遅延なく提示いたします。




コメント
もっと見る